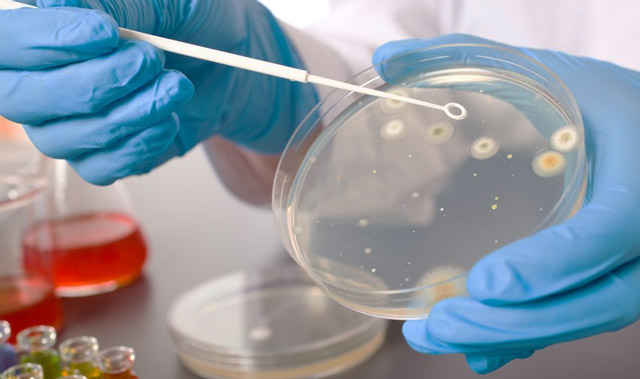
3423423422222

Кишечным гриппом называют группу вирусных инфекционных заболеваний, протекающих с симптомами острого гастроэнтерита. Они были так названы по причине схожести ряда клинических признаков с респираторным гриппом:
- Осенне-зимняя сезонность;
- Высокая заразность;
- Наличие катаральных изменений в ротоглотке;
- Один из путей передачи – воздушно-капельный;
- Средняя продолжительность болезни не превышает 7-ми дней.
Наиболее подвержены инфекции дети в возрасте до 3-х лет, в этой возрастной группе более половины случаев гастроэнтерита обусловлены возбудителями кишечного гриппа. Младенцы до года, находящиеся на грудном вскармливании болеют им крайне редко, благодаря защитным антителам, которые они получают от матери. Среди детей на искусственном вскармливании случаи кишечного гриппа регистрируются, начиная с 3-х месячного возраста. По мере взросления заболеваемость несколько снижается, что связано с приобретением иммунитета после первого эпизода болезни.
К 15-17-ти годам у 90% молодых людей в крови обнаруживаются антитела к вирусам кишечного гриппа, свидетельствующие о перенесенной ранее инфекции.
Взрослые люди болеют кишечным гриппом несколько реже: у них его доля среди острых кишечных инфекции составляет около 25%.
Наибольшую опасность вирусные гастроэнтериты представляют для больных с иммунодефицитными состояниями:
- ВИЧ-инфицированных;
- Принимающих цитостатики, глюкокортикоиды;
- Онкологических больных;
- Беременных женщин;
- Людей с трансплантированными органами;
- Больных с хроническими соматическими заболеваниями, особенно пищеварительной системы.
Кроме того, вирусы кишечного гриппа участвуют в развитии «диареи путешественников». Резкая смена климатической зоны и переход на непривычные продукты питания приводят к снижению факторов иммунной защиты, что дает возбудителю возможность беспрепятственно размножаться в кишечнике. У людей пожилого возраста заболеваемость несколько повышается из-за постепенно нарастающего иммунодефицита, который закономерно развивается к старости.
Возбудитель
Кишечный грипп вызывают вирусы, способные размножаться в клетках эпителия тонкого кишечника. Причиной инфекционного гастроэнтерита становятся:
- Ротавирус;
- Норволк вирусы из семейства калицивирусов;
- Аденовирусы;
- Астровирусы;
- Торовирусы.

Большую роль играет водный путь передачи, например, ротавирус сохраняется в холодной воде в течение месяцев. Описаны вспышки ротавирусного гастроэнтерита, связанные с употреблением зараженной бутилированной воды.
Ниже рассмотрим наиболее часто встречающихся возбудителей, симптомы и лечение кишечного гриппа.
Ротавирус
Ротавирус
Вирус был обнаружен в 70-х годах 20-го века в клетках эпителия 12-перстной кишки детей, погибших от острого гастроэнтерита. Вирионы имеют форму колеса, внутри которого располагается молекула РНК – наследственная информация возбудителя. Снаружи она покрыта двойной белковой оболочкой, к которой крепятся рецепторы адгезии. Они избирательно связываются с клетками кишечного эпителия и верхних дыхательных путей, закрепляя вирион на поверхности слизистой оболочки. Рецепторами обусловлена тропность ротовируса к тонкому кишечнику и ротоглотке. Исследования последних лет свидетельствуют, что вирус в разгар болезни выходит в кровяное русло и разносится по всем органам человека. В частности, ротавирусная инфекция поражает печеночные клетки, с чем связано стойкое повышение печеночных ферментов после перенесенной болезни.
Ротавирус весьма устойчив во внешней среде, особенно в холодное время года. Он сохраняется до одного месяца на овощах и фруктах, до 2-х недель на постельном белье, одежде, коврах. Вирус не разрушается под действием дезинфицирующих растворов, ультразвука, низких температур, но быстро погибает при кипячении. Его поражающая способность увеличивается при обработке ферментами желудка и 12-типерстной кишки.
Норволк вирус
Малоизученный вирус, послуживший причиной вспышки «рвотной болезни» (иначе – «желудочный грипп») в американском городе Норволк. Вирионы мелкие, состоят из одной цепочки РНК, окруженной белковой капсулой. Возбудитель устойчив во внешней среде, не погибает при воздействии дезинфицирующих растворов, чувствителен к нагреванию. Инфекция передается водным и пищевым путями через зараженные морепродукты.
Аденовирусы
Аденовирусы – крупные ДНК-содержащие вирусы, чрезвычайно устойчивые во внешней среде. Большинство из них вызывают инфекцию верхних дыхательных путей в сочетании с конъюнктивитом, но существуют 2 типа (серовары 40 и 41), которые избирательно поражают кишечный эпителий. Аденовирусы опасны для детей в возрасте до 2-х лет, большинство взрослых приобретают к ним стойкий иммунитет.
Передается инфекция фекально-оральным путем, через загрязненную воду, пищу, бытовые предметы. На аденовирусы не действуют большинство дезинфектантов, они успешно выдерживают замораживание и сохраняются в воде до 2-х лет. Вирионы погибают при нагревании свыше 60-ти градусов С и при воздействии ультрафиолетового излучения.
Механизм развития болезни
Вирус попадает в ротовую полость человека с зараженной пищей, водой, грязными руками или с капельками слюны при аэрогенном пути передачи и заглатывается им. Вирионы устойчивы к кислотам, потому легко преодолевают кислую среду желудка и попадают в 12-перстную кишку. Главная функция 12-перстной кишки и тонкого кишечника в целом – это ферментативное расщепление питательных веществ на мельчайшие составные части и их дальнейшее всасывание в кровь.
Схема желудочно-кишечного тракта
Площадь этого отдела желудочно-кишечного тракта колоссальная: тонкий кишечник имеет протяженность около 5 метров и на всей своей поверхности усеян ворсинами – выростами слизистой оболочки. В каждую ворсину со стороны кишечной стенки заходят кровеносные сосуды – в них всасываются питательные вещества. Со стороны полости кишечника ворсины покрыты особыми эпителиальными клетками – энтероцитами. Энтероциты имеют вытянутую форму и на полюсе, обращенном в просвет кишки у них, в свою очередь, располагаются выросты клеточной мембраны в виде микроворсинок. Таким образом, всасывающая площадь кишечника дополнительно увеличивается в 30 раз.
Вирусы кишечного гриппа проникают внутрь энтероцитов, сбрасывают белковую оболочку и направляют свою наследственную информацию (ДНК или РНК) в ядро клетки. Происходит запуск синтеза вирусных белков и этот процесс полностью подавляет все остальные клеточные процессы. В итоге в энтероците накапливается огромное количество составных частей вирионов, происходит их дальнейшая сборка и выход во внешнюю среду. Вирусные частицы разрывают клеточную мембрану, что приводит к окончательной гибели клетки.
Происходит массивное заражение соседних клеток, они погибают и слущиваются с основной пластики ворсин. Как следствие – нарушаются процессы приклеточного пищеварения, расщепления олигосахаридов на моносахариды и их всасывание. Углеводы накапливаются в просвете кишки, увеличивая осмотическое давление химуса – кашицы из частично переваренной пищи. Повышенная концентрация олигосахаридов приводит к компенсаторному поступлению в полость кишечника воды, чтобы разбавить химус и нормализовать его осмотическое давление. Большой объем жидкого содержимого в просвете кишки раздражает нервные окончания в ее стенке и происходит рефлекторное усиление перистальтики.
В итоге, разбавленный химус быстро проходит через всю кишечную трубку, избыточная жидкость не успевает всосаться и развивается диарея – обильный жидкий стул. Переполнение 12-типерстной кишки, в свою очередь, нарушает нормальное продвижение пищевого комка из желудка. В желудке возникают антиперистальтические волны и пища находит выход через пищевод в виде рвоты.
В ответ на гибель клеток и размножение вируса иммунные клетки начинают вырабатывать защитные антитела. Они связывают вирусные частицы, постепенно очищая от них инфекционный очаг. Часть вирионов выходит наружу вместе с каловыми массами, чтобы продолжить цикл своего развития.
Клиническая картина
Инкубационный период кишечного гриппа зависит от возбудителя. При ротавирусной инфекции от момента заражения до первых признаков проходит от 1-го до 7-ми дней, аденовирусная инфекция развивается дольше – 8-10 дней. Больной начинает выделять возбудителя во внешнюю среду уже в конце стадии инкубации, до появления типичной клинической картины.
Заболевание начинается остро с повышения температуры тела до 38-39 градусов С, рвоты съеденной пищей и жидкого стула. Иногда его начало происходит постепенно: сначала развиваются признаки интоксикации – слабость, головная боль, отсутствие аппетита, повышенная утомляемость, лихорадка. На следующий день к ним присоединяются жидкий стул, тошнота и рвота. Перечисленные симптомы кишечного гриппа характерны для типичного течения болезни. Также инфекция может протекать со стертыми клиническими признаками: болью в животе, урчанием, снижением аппетита, невыраженной слабостью. В ряде случаев развивается носительство, при котором внешне здоровый человек выделяет вирус с фекалиями.

Рвота возникает одновременно с поносом, но может присоединиться позднее. Сначала рвотные массы содержат съеденную ранее пищу, затем выделяется только желудочный сок. Больной не может пить в достаточном объеме – жидкость раздражает стенки кишечника и возникает повторная рвота. В результате организм только теряет воду без возможности пополнить ее запас в организме.
Начальный признак обезвоживания – это сухость слизистых оболочек и выраженная жажда. Язык становится сухим и шершавым, снижается слюноотделение, тускнеет конъюнктива глаз. Сухость кожи, снижение ее тургора, резкая слабость, невыраженные судороги икроножных мышц – это признаки потери 4-6% жидкости организма. Дальнейшее прогрессирование процесса приводит к осиплости голоса, падению артериального давления, снижению объема выделяемой мочи, потере сознания. Крайняя степень обезвоживания – это спутанность сознания, заострение черт лица, синюшный оттенок кожи, понижение температуры тела до 35 градусов С. Она соответствует стадии гиповолемического шока и быстро приводит к смерти больного. У детей описанные изменения могут развиться в течение суток при выраженной диарее и частой рвоте.
При ротавирусной инфекции к симптомам поражения желудочно-кишечного тракта присоединяется катаральный синдром. Он проявляется гиперемией зева, зернистостью задней стенки глотки и болью при глотании. Возникает заложенность носа со скудным слизистым отделяемым, у маленьких детей иногда развивается острый отит.
Лихорадка при кишечном гриппе редко сохраняется более 2-4-х дней, ее наличие после этого срока может говорить о присоединении бактериальной микрофлоры. Аденовирусная инфекция характеризуется более тяжелым и упорным течением, нежели ротавирусная. Норволк-инфекция, как правило, протекает без диареи: с лихорадкой, интоксикацией и рвотой. При ротавирусной инфекции рвоты может не быть, в этом случае говорят о ее кишечной форме.
Диагностика

Окончательный диагноз устанавливается по результатам лабораторных исследований. В каловых, рвотных массах с помощью ПЦР обнаруживают ДНК/РНК вируса или антитела к нему методом ИФА. В крови больного специфические антитела появляются на 5-10-й день болезни, их наличие и титр устанавливают методами ИФА, РНГА. Для острой инфекции характерно резкое повышение Ig М первые две недели инфекционного процесса, после чего титр их снижается и им на смену приходят IgG. Последние циркулируют в крови несколько лет после перенесенного кишечного гриппа.
Для определения тяжести состояния больного и дополнительного обоснования диагноза врач назначает:
- Общий анализ крови – при обезвоживании увеличивается гематокрит и содержание всех клеточных элементов крови. В пользу вирусной инфекции говорит снижение общего количества лейкоцитов и преобладание лимфоцитов, и моноцитов.
- Биохимический анализ крови – при ротавирусной инфекции растет концентрация в крови АЛТ, АСТ, иногда – непрямой фракции билирубина.
- Общий анализ мочи – при обезвоживании снижается объем выделяемой мочи и увеличивается ее плотность.
Лечение
Больных кишечным гриппом госпитализируют в стационар при среднетяжелом и тяжелом течении болезни, а также по эпидемическим показаниям.
К ним относятся все случаи, при которых больного нельзя изолировать от окружающих: проживание в казарме, доме-интернате, детском доме. Госпитализируются работники пищевых предприятий, водоканалов, воспитатели детских дошкольных учреждений и медперсонал детский отделений, так как они представляют повышенную опасность для распространения инфекции.
Лечение кишечного гриппа включает в себя щадящую диету, восстановление водно-электролитного баланса, стимуляцию интерфероногенеза и дезинтоксикацию. Специфическая противовирусная терапия на сегодняшний день не разработана. Диета при кишечном гриппе направлена на нормализацию пищеварения.
Необходимо исключить из рациона продукты, раздражающие желудочно-кишечный тракт:
- Сырые овощи и фрукты;
- Натуральные соки;
- Зерновой хлеб;
- Цельное молоко, сливочное масло, сыры;
- Злаки;
- Копчености;
- Бобовые;
- Консервированные продукты;
- Шоколад и кофе;
- Жирное мясо;
- Приправы;
- Алкоголь.
Можно употреблять в пищу каши-размазни (манную, овсяную, рисовую), приготовленные на воде или разбавленном молоке без добавления сливочного масла. Необходимо включать в рацион супы на некрепком бульоне из диетического мяса: курицы без кожи, индейки, кролика, постной говядины. Разрешается есть белый хлеб, в том числе в виде сухарей, котлеты из нежирного мяса, приготовленные на пару. Пищу следует принимать маленькими порциями, часто, в теплом виде.
Из медикаментозных препаратов назначают:
- Растворы электролитов (физраствор, трисоль, тетрасоль, лактасоль) внутривенно-капельно и внутрь (регидрон) – восстанавливают водно-электролитный баланс;
- Энтеросорбенты – связывают токсины и лишнюю жидкость в просвете кишечника (смекта, энтеросгель);
- Ферменты поджелудочной железы – улучшают расщепление питательных веществ в тонком кишечнике (панкреатин);
- Индукторы интерфероногенеза – усиливают выработку защитных антител (циклоферон);
- Препараты бифидо- и лактобактерий – восстанавливают нормальную микрофлору кишечника (аципол, бифиформ).
Лечение кишечного гриппа при беременности проводят препаратами, безопасными для плода. В основном женщинам назначают строгое соблюдение диеты, растворы электролитов и средства для восстановления кишечного биоценоза. Лечить кишечный грипп антибиотиками нерационально, так как они не действуют на причину болезни – вирусы.
Больных выписывают после исчезновения симптомов кишечного гриппа, в среднем через 5-7 дней от начала болезни. После выздоровления в течение 2-3-недель им необходимо соблюдать лечебную диету, постепенно переходя на привычный рацион питания.
Специфическая профилактика на сегодняшний день разработана только в отношении ротавирусной инфекции. Вакцина есть в продаже, но не входит в национальный календарь прививок. Неспецифическая профилактика заключается в тщательном соблюдении правил личной гигиены и употреблении только кипяченной воды.
Основные осложнения кишечного гриппа – это обезвоживание и дегидратационный шок. У взрослых инфекция редко протекает настолько тяжело, но у детей и пожилых людей подобные состояния развиваются в короткие сроки. Отсутствие медицинской помощи в таких случаях быстро приводит к смерти от большой потери воды.
Видео: кишечный грипп, ротавирус – доктор Комаровский
https://youtube.com/watch?v=WsqASK-1ylw
Мнения, советы и обсуждение:
Источник
Кишечный грипп еще 20-30 лет назад вообще не выделяли как отдельное заболевание. Это была простая кишечная инфекция, одна из многих. Однако в 70-х годах ХХ века был открыт ротавирус – возбудитель кишечного гриппа, после чего болезнь получила свое название.
Что же это такое? Кишечный грипп – упрощенное название гастроэнтерита или ротавирусной инфекции, возбудителем которой является ротавирус. Его размножение приводит к воспалению ЖКТ. В этой статье мы поговорим о том, когда ставят диагноз «кишечный грипп», симптомы и лечение этой неприятной болезни, а также расскажем о том, чем заболевание опасно для взрослых и детей.
Почему дети болеют чаще взрослых?
То, что кишечный грипп у детей проявляется намного чаще, чем у взрослых, является следствием особенности детского организма, заключающейся в низком уровне кислотности желудочного сока. Организм взрослых в некоторой степени защищен от ротавирусов благодаря более высокой кислотности, а также достаточному количеству выработки иммуноглобулина IgA.
- Определенную роль играет и привычка детей брать в рот игрушки и другие предметы.
Противовирусные средства бессильны перед ротавирусом. Кишечный грипп у детей может быть очень опасен. Появление диареи и частой рвоты должно стать поводом для немедленного обращения к педиатру. Важным моментом защиты малышей от инфекции является профилактика.
Как можно заразиться?
Почему возникает кишечный грипп, и что это такое? Возбудителем заболевания является ротавирус. Впервые возбудитель заболевания был обнаружен в 1973 году в биоптате тонкого кишечника у детей, больных гастроэнтеритом. Основным источником инфекции является больной человек или вирусоноситель. Микробы, попадая в организм человека, размножаются в клетках слизистой оболочки пищеварительного тракта и выводятся в окружающую среду вместе с калом. Выделение вируса происходит сразу после заражения.
Основной путь заражения – при употреблении пищи, которая заражена вирусом, недостаточно хорошо обработана при приготовлении и когда игнорируются элементарные правила личной гигиены. Это тоже «болезнь грязных рук», как и большинство кишечных заболеваний. Хорошей средой для развития ротавирусной инфекции является вода, молочные продукты.
Чаще всего кишечным гриппом заболевают дети от полугода до 3-х лет. Дети старшего возраста болеют не часто, у них формируется относительно стойкий иммунитет.
Симптомы кишечного гриппа
В случае кишечного гриппа у взрослых симптомы можно условно разделить на две группы. К первой группе относятся те признаки, что характерны для обычной простуды или же гриппа. Вторая группа содержит симптоматику, связанную с расстройствами желудка и кишечника.
Основными признаками кишечного гриппа у взрослых являются:
- тошнота, рвота без крови и слизи;
- слабость, ломота в теле, болезненные ощущения в мышцах;
- кашель (как правило, сухой);
- заложенность носа и насморк;
- краснота, першение и боль в горле;
- субфебрильная или высокая температура;
- конъюнктивит;
- желудочно-кишечные расстройства, спазмы в животе, метеоризм, при этом отмечается частый светлый
- пенящийся стул с неприятным запахом;
- при тяжелом развитии болезни заметны признаки обезвоживания.
Инкубационный период при кишечном гриппе составляет от нескольких часов до пяти дней. Именно в течение указанного времени проникшая в организм инфекция достигает желудочно-кишечного тракта и начинает активно размножаться там. То, насколько быстро инфекция завладеет организмом, зависит от количества вируса-возбудителя в нем. Тяжесть протекания гастроэнтерита также зависит от этого фактора. Сложнее всего переносят болезнь дети и пожилые люди.
Длительность болезни у взрослых людей в среднем составляет неделю, но полное выздоровление наступает только через 5-7 дней после острой стадии болезни. Тем не менее, человек все еще может быть переносчиком заболевания, поэтому стоит придерживаться строгих правил личной гигиены, особенно в общественных местах.
Осложнения
Иногда при кишечном гриппе, вследствие большой потери жидкости может наступить дегидратация организма, что требует особого внимания и тщательного подбора лекарств. О дегидратации могут свидетельствовать впалые глаза, головокружение, жажда, клейкость во рту, сухость кожных покровов.
Дегидратацию организма можно ослабить, предлагая больному теплое питье и немного диетической пищи, содержащей бананы, рис, яблочный сок, сухарики. Это противовоспалительная диета.
Как лечить кишечный грипп?
Антибиотики не используются из-за неэффективности. В случае кишечного гриппа лечение направлено на ликвидацию симптомов и преследует определенные цели:
- устранение обезвоживания;
- поднятие иммунных сил организма;
- восстановление водно-электролитного баланса;
- нормализация функции кишечника;
- восполнение недостатка ферментов.
Для достижения поставленных задач применяют следующие группы лекарственных средств:
- энтеросорбенты;
- вяжущие препараты растительного происхождения;
- ферментативные лекарства;
- препараты, нормализующие микрофлору (про- , пре- и эубиотики);
- жаропонижающие;
- витаминные комплексы.
Схема лечения
Специфического лечения кишечного гриппа у взрослых пока не существует. Терапия в домашних условиях направлена на снижение интоксикации, нормализации водно-солевого обмена, который нарушается при диарее и рвоте. То есть лечение в основном симптоматическое, направленное на снижение негативного воздействия вируса на организм.
Общие принципы лечения ротавирусной инфекции:
- В первую очередь необходима регидратационная терапия, для чего 1 пакетик Регидрона растворяется в литре кипяченой воды и выпивается в течение дня каждые полчаса. Взрослым вне зависимости от тяжести состояния после рвоты или стула выпить 200 мл. раствора, поскольку потери жидкости должны восполниться в первые 6 часов. Детям с частой рвотой и диареей показана госпитализация.
- Назначение сорбентов (Активированный уголь, Энтеросгель, Смекта) и медикаментозных препаратов, снимающих вздутие и улучшающих микрофлору кишечника.
- Также следует принимать лекарственные препараты с пищеварительными ферментами – Креон, Панкреатин, Мезим форте.
- Соблюдение режима питания. При кишечном гриппе рекомендуется щадящий режим питания, исключающий жареные, жирные, молочные продукты, газированные напитки и соки. Желательно употреблять каши, приготовленные на воде, овощные супы, компоты из сухофруктов, кисели.
- При выраженной рвоте возможно применение противорвотных препаратов.
- При сильном поносе с температурой врачи обычно назначают Фуразолидон или Энтерофурил.
- Показан полупостельный режим и изоляция больного от здоровых людей.
- После острой фазы гриппа нужно восстановить микрофлору кишечника. Для этого используют пробиотики – Линекс, Бифиформ, Хилак форте и т.д.
- Если симптомы ярко выражены – показана госпитализация в стационар.
Поскольку этиотропного лечения этого заболевания нет, то большое значение имеет профилактика кишечного гриппа. Мероприятия профилактического характера включают в себя весь комплекс, применяемый при кишечных инфекциях: регулярное мытье рук, уборка помещений с дезинфицирующими и антисептическими растворами, обработка посуды и продуктов, максимально возможная изоляция больных от здоровых. При соблюдении этих правил распространение болезни удается остановить.
Питание
Диета при кишечном гриппе обязательна: больной на протяжении всего курса лечения не должен есть острую и жареную пищу, следует употреблять больше овощных супов, пить кисель и компот.
При поносе и рвоте организм обезвоживается, поэтому нужно употреблять больше жидкости. Для того чтобы в кишечнике не собирались газы, нужно есть кисломолочные продукты, гренки и сухари.
Источник